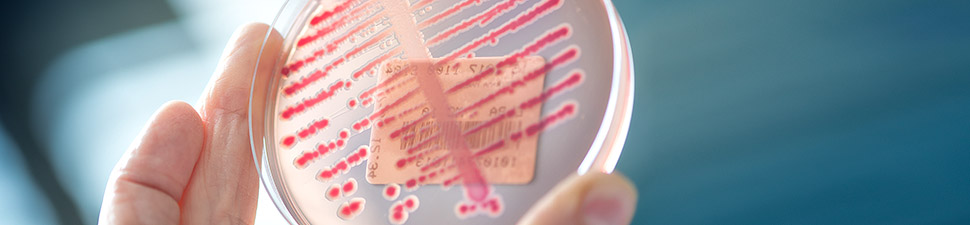

The diagnostic section of the Institute of Microbiology performs a broad spectrum of in vitro diagnostic tests in the area of bacteriology, mycobacteriology, mycology, parasitology, serology, virology and molecular diagnostic.
Apart from its mission in basic research and in teaching, the Institute provides microbiological diagnostics for hospitalized patients as well as for external patients. The diagnostic activity, integrated into the Department of laboratory medicine and pathology of the CHUV, is recognized by Swissmedic (authorization 511183-102604371), and is accredited under SN EN ISO 15189:2013 with Pr Gilbert Greub as technical expert and Mrs Sarah Chappuis as responsible for quality assurance.
To submit samples for microbial diagnostics, please use the CHUV-IMU order form No 151 (provided upon request to 021-3144107). Our panel of biomedical experts is available for advice.
The Institute serves as a reference center for several pathogens, including intracellular bacteria and human papillomaviruses, and is active in the development of new or improved diagnostic tests through R&D.